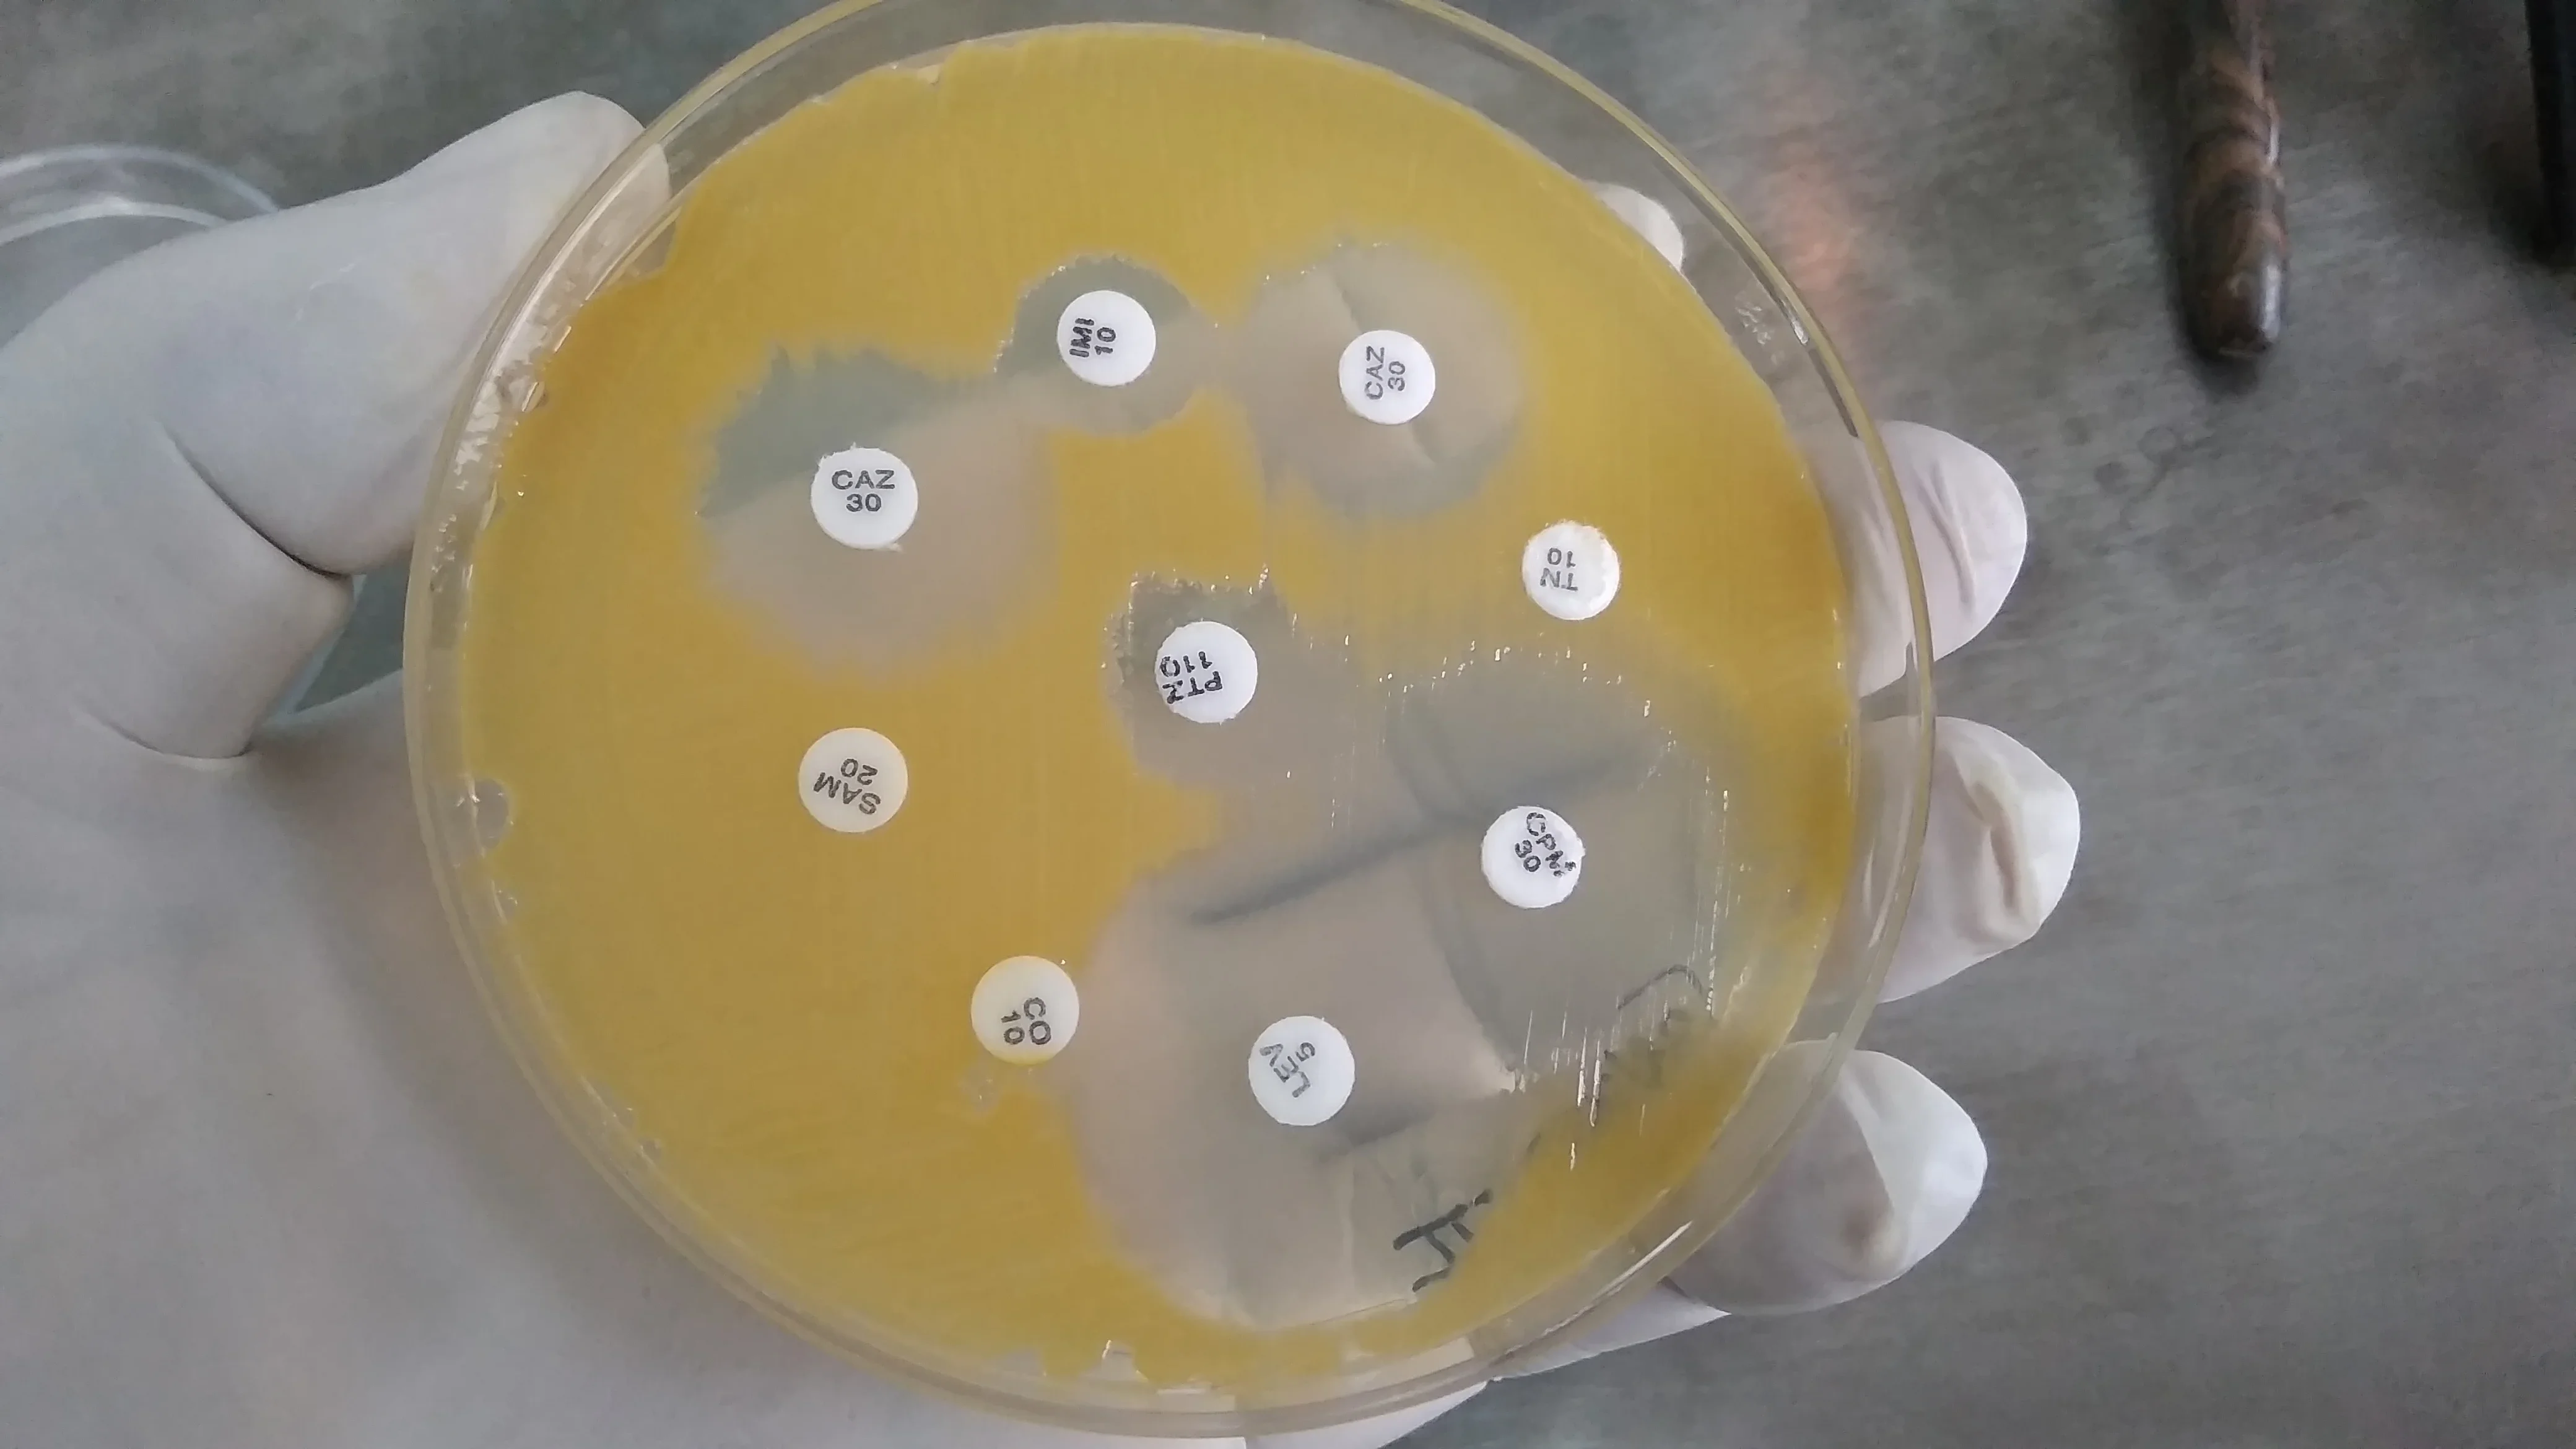
Размыт фон

Световната здравна организация официално обяви устойчивостта към антимикробни лекарства за извънредна ситуация в областта на глобалното здраве – ход, който засилва призивите за незабавни международни действия, докато лекарствено-резистентните инфекции продължават да отнемат животи с тревожна скорост. Решението, обявено през изминалия уикенд, стъпва върху години на нарастващи предупреждения от здравните власти и съвпада с нови данни, според които антибиотичната резистентност се развива по-бързо, отколкото се появяват нови терапии.
Нарастващи загуби: когато инфекциите изпреварват лечението
Ключово изследване, публикувано в "The Lancet", показва, че бактериалната резистентност към антимикробни средства е била пряка причина за около 1,27 милиона смъртни случая в световен мащаб през 2019 г. и е допринесла за общо 4,95 милиона смърти през същата година – повече, отколкото са жертвите на ХИВ/СПИН или малария. Това поставя резистентните инфекции сред водещите причини за предотвратима смърт.
Обновените оценки, публикувани отново в "The Lancet" през 2024 г., сочат, че през 2021 г. 1,14 милиона смъртни случая са били директно свързани с бактериална антимикробна резистентност. Прогнозите са още по-мрачни: ако не бъдат предприети решителни мерки, до 2050 г. годишният брой смъртни случаи може да достигне 1,91 милиона. Зад тези числа стоят реални истории – от обикновени инфекции на пикочните пътища, станали трудно лечими, до следоперативни инфекции, при които "обичайните" антибиотици вече не действат.
Глобалната карта на резистентността: една от шест инфекции не се повлиява от антибиотик
Доклад на СЗО, публикуван през октомври 2025 г., показва, че през 2023 г. приблизително всяка шеста лабораторно потвърдена бактериална инфекция в света е била устойчива на стандартното антибиотично лечение. За периода 2018–2023 г. е регистрирано повишаване на резистентността при повече от 40% от наблюдаваните комбинации "патоген–антибиотик". С други думи – все по-голяма част от познатите ни бактерии "се научават" да преживяват лекарствената атака.
Най-високи нива на резистентност са установени в регионите на Югоизточна Азия и Източното Средиземноморие, където около една трета от докладваните инфекции показват устойчивост към поне един антибиотик. Особено притеснителна е нарастващата устойчивост към карбапенеми – група мощни антибиотици, смятани дълго време за "последна линия" на защита. Когато и те престанат да действат, възможностите за лечение рязко се свиват, а в много държави с ниски доходи алтернативите са или недостъпни, или твърде скъпи.
"Устойчивостта към антимикробни препарати изпреварва напредъка на съвременната медицина и застрашава здравето на семействата по целия свят", предупреди генералният директор на СЗО Тедрос Адханом Гебрейесус в доклад от октомври 2025 г., подчертавайки, че без координиран отговор рискуваме да се върнем в епоха, когато рутинни операции и инфекции отново са смъртоносни.
Формиране на глобален отговор: от ООН до Давос и националните парламенти
Решението на СЗО идва в контекста на редица политически ангажименти през последните години. През 2024 г. Общото събрание на ООН прие политическа декларация за антимикробната резистентност (АМР), в която държавите–членки поеха ангажимент да намалят с 10% смъртността, свързана с АМР, до 2030 г. В началото на 2026 г. Изпълнителният съвет на СЗО одобри проект за обновен Глобален план за действие по АМР за периода 2026–2036 г., който се очаква да бъде окончателно приет на Световната здравна асамблея през май.
На Световния икономически форум в Давос през януари над 50 организации – от фармацевтични компании до банки и граждански организации – подписаха "Давоския договор за АМР", с който се ангажираха с междусекторно сътрудничество за справяне с кризата. В САЩ през март беше внесен законопроектът "SUPER BUGS Act", насочен към засилване на сътрудничеството в изследванията на лекарствено-резистентните инфекции и стимулиране на разработката на нови терапии. Междувременно екип от Калифорнийския университет в Сан Диего представи CRISPR-базиран инструмент, който може да лишава бактериални популации от гени за резистентност – потенциално нов фронт в битката със "супербактериите".
Гонка с времето: твърде малко нови антибиотици, твърде бързо нарастваща резистентност
На фона на нарастващата резистентност, разработката на нови антибиотици върви болезнено бавно. Според оценката "AMR Benchmark 2026" в света има едва седем иновативни антибиотични проекта в късни фази на клинично развитие, насочени към най-опасните лекарствено-устойчиви патогени. Това е недостатъчно, за да компенсира загубата на ефективност при съществуващите лекарства.
СЗО публикува нови целеви продуктови профили за спешно необходими антибиотици, за да насочи фармацевтичните компании към патогените и характеристиките, които са най-критични от гледна точка на общественото здраве. Експерти обаче предупреждават, че без устойчиво финансиране и промяна в бизнес моделите за антибиотици фармацевтичната индустрия ще продължи да избягва този рисков сегмент. Резултатът може да бъде свят, в който банални инфекции – като пневмония или инфектирани рани – отново стават трудно лечими.
Следващите стъпки: среща на върха в Абуджа и тест за политическата воля
За юни в Абуджа, Нигерия, е насрочена 5‑ата Министерска конференция на високо равнище по устойчивостта към антимикробни лекарства. Там се очаква световните лидери да направят преглед на напредъка по поетите ангажименти и да потвърдят или актуализират целите си. Ключови теми ще бъдат финансирането на нови лекарства и диагностични тестове, контролът върху употребата на антибиотици в човешката и ветеринарната медицина и укрепването на здравните системи в държавите с ниски и средни доходи.
Вижте още подобни статии
 Дигитализацията в здравеопазването: Грешките при отпускане на лекарства спаднаха с 98%
Дигитализацията в здравеопазването: Грешките при отпускане на лекарства спаднаха с 98% Плувен маратон „Цонка Тодорова“ 2026: Плувай с кауза за онкоболни в Бургас
Плувен маратон „Цонка Тодорова“ 2026: Плувай с кауза за онкоболни в Бургас Медицински пробив в Бургас: Лекари излекуваха рядка листериоза при дете
Медицински пробив в Бургас: Лекари излекуваха рядка листериоза при дете Безопасно ли е морето? РЗИ-Бургас с важни съвети за мазутните топчета
Безопасно ли е морето? РЗИ-Бургас с важни съвети за мазутните топчета
Обявяването на АМР за извънредна ситуация в глобалното здравеопазване поставя политическа и морална рамка: антибиотичната резистентност вече не е "тиха криза", а призната глобална заплаха, съпоставима с пандемии и други големи здравни предизвикателства. Дали светът ще успее да навакса изоставането в "гонката" с микробите, ще зависи от това доколко декларациите ще се превърнат в финансирани програми, променени практики и нови решения в лабораториите и болниците.

Коментари (83)
user282@abv
07.04.2026, 12:21Аби сериозно ли? Пак ли трябва да ни спасяват от нашите си
maria215@bg
07.04.2026, 12:22абе хора, успокойте се малко! да, ситуацията е зверска, ама да хвърляме вина веднага на русия... не ЗНАМ, мисля че е по-скоро въпрос на глобално пренаселение и неправилни практики. вижте колко антибиоти
mega_tiger378
07.04.2026, 12:23абе, user282@abv, к'во значи "от нашите си"? да не би да си мислиш, че тая резистентност се е появила от нищото? има си причини, хора! прекалено много антибиотици, неправилна употреба - и туй си е наш проблем. не казвам, че трябва да висим само на чужди конци, ама да се правим на всезнаещи и да отричаме проблема... аз лично мисля, че доброто сътрудничество с европа и сзо в тая ситуация е най-разумно. те имат опит и ресурси, ние - мозъци и желание.
ivan207@abv
07.04.2026, 12:25Абе, user282@abv, "от нашите си"? Ти май малко си живееш в блажено неведение, приятелю. Да, горките ние пак ще трябва да разчитаме на някой друг, защото явно не сме много добри в предпазването на собственото си здраве и бъдеще. Ама кой да ги слуша тия дето крещят за "национален суверенитет" и се правят на големи все пак, докато антибиотиците стават безполезни?
Млад_Софиянец
07.04.2026, 12:25абе, user282, к'во значи "от нашите си"? да не би случайно ру
Стар_Бургазлия
07.04.2026, 12:25Абе вие сериозни ли сте?! "Пак ли трябва да ни спасяват от нашите си" - ама хайде бе, user282@abv, кой друг ще ни спаси? Аз пък си мисля, че пак някой наш "приятел" отвъд реката се е почукал на вратата с евтини боклуци и сега СЗО трябва да чисти след него. Не казвам, че вси
Стар_Човек
07.04.2026, 12:25Абе, user282@abv, мисля, че си малко прекалено циничен. Да, факт е, че често разчитаме на европейските институции да ни помагат с различни проблеми – и това не е срамно! По-скоро трябва да се фокусираме
Васлав
07.04.2026, 12:26Ааа, пак ли ние сме виновни? Аман от тоя попу
mega_wolf61
07.04.2026, 13:10Ужас! 😱 Тази резистентност е супер притеснителна... Сега ще требва пак Европа да ни
Ивашко
07.04.2026, 13:11Ей, mega_wolf61, ама че правилно каза! И Европа пак ще трябва да се намеси… Ясно е кой каквото иска да доказва, ама виж сега – тоя проблем го има от години! Колко пъти сме чували за антибиотична резистентност? Милиони са жертвите вече, а ние си мислим, че България ще се оправи с бабини рецепти и молитви!
yxeao365
07.04.2026, 13:11Абе, mega_wolf61, прав си, ужасно е. Ама да се надяваме, че Европа ще помогне с финансиране и
Stoyan85
07.04.2026, 13:13Абе пич, mega_wolf61, напълно прав си, ужас е! 😱 И да, Европа трябва да помогне – имаме нужда от солидарност, особено в такива ситуации. Ама да не се забравя и нашата роля - да подкрепяме българските лекари и изследванията ни, да правим
Честит_Българин
07.04.2026, 13:29Еее, пак ли ние сме някаква глобална тежест?
Вано
07.04.2026, 13:31Абе, Честит_Бългярин, к'ви сте постоянно недоволни, ма?! Глобална тежест ли? Ами да, ама щом СЗО го казва - значи има защо! Не е само нас ни хваща, виж сега. Да не говорим колко антибиотици се изписват безконтролно по целия свят. Това е, брато, като с Планетата - ако продължаваме да я третим зле, и тя ще ни отвърне!
ultra_master
07.04.2026, 13:31Абе, Честит_Българин, стига вече с тия "пак ли ние". Глобална тежест е да СИ в Русия, дето нищо не функционира 🤬
real_hero
07.04.2026, 13:33Абе, Честит Българин, да не обиждам никой, ама... кво искаш? Да се оплакваме ли пак за нещо? Ясно е, че сме малка държава и винаги ще има някакви "глобални тежести", които се стоварват върху нас. Но туй с антибиотичната резистентност не е шега работа – наистина е страшно. 🤦♂️
dbbjp988
07.04.2026, 13:33Абе Честит_Българин, к'ви тежести бе?! Ама виж сега – това е глобално, брат! И тук ни касае пряко, ясно ли ти стана? Дали пък някой си мисли, че щом сме "малка" държава, няма да ни засегне?! Пак Русия няааа, пак нещо световно! Трябва да се захванем яко
D37BDE010E
07.04.2026, 13:33Честит Българин, абе дай го на! Пак се оплакваме за нещо. Явно, ако не си правим профилактики и пием антибиотици
Мидар
07.04.2026, 13:34Абе, Честит_Българин, кви са ти тия приказки? "Глобална тежест"?! Да, може би сме малка държава, ама да се правим на ударени е все едно да си заравяш главата в пясъка. Видя ли колко смъртти има годишно заради тая антибиотична резистентност? Това не е шега работа!
Лош_Патриот
07.04.2026, 13:34Абе, Честит_Българин, к'ви сте всичките напети! "Пак ли ние сме глобална тежест?" Я виж сега какво става, бе! СЗО обяви криза, ама дали си давате сметка? Не е само за нас. И не може веднага да обвиняваш някого. Да, Европа трябва да вземе мерки, разбира се - все пак ние сме част от нея и защитаваме общите интереси! Ама тая Русия... да не почвам аз сега! Виж колко години ги заливаха с пропаганда за "традиционни ценности" и как да си помагаме сами, а сега гледай какво се получава – все
Ивадар
07.04.2026, 13:30Хм... Явно ще има още работа за европейските агенции, докато някои хора тук продъл
Vasil90
07.04.2026, 13:32Абе, Ивадар, к'во да разбират някои хора от глобални кризи бе?! 🤦♀️ Европа ще се
1295C1C6
07.04.2026, 13:33абе, ивадар, сериозно ли казваш?! евроагенциите да работ
Vasil17
07.04.2026, 13:33ааа, ивадар, право си... трябва да се вземат мерки яко. европа да помага с контрол и
F397D6B7A7
07.04.2026, 13:34Пфуууу… Ивадар, браво, точно така! "Някои хора тук продължават"... Ами да, продължават да плюят по всичко европейско, да ронят сълзи за някакви си “изгодни” руски лекарства и да се правят на ударени, когато става ясно, че тези изгоди са всъщност смъртоносни!
ivan150@eu
07.04.2026, 13:35Евала на Ивадар за коментара! Напълно съм съгласен – работа колкото искат има пред европейските агенции. И да, наистина е притеснително, ама и малко се усещам безпомощен като чета тези новини. 1,1 милиона смъртни случая годишно… това е страшно!
Гечев
07.04.2026, 13:39Абе хора, сериозно ли? Антибиотици, дето ги пием кат' вода... Явно трябва да си гледаме повече работа с хигиената и да не се самолекуваме, че после стават такива драми. Иначе, СЗО е прав - глобален проблем е, ама да не се правим на ударени пак! Европа трябва да вземе мерки, но и ние като българи да си поемем от
Добър_Човек
07.04.2026, 13:41Абе, Гечев прав си за хигиената и самолекуването - направо ме е яд, че трябва да го казваме пак! Но все пак, Ралов май има право... Дали ня
Мичев
07.04.2026, 13:43Гечев, бате, точно! Иначе, да си гледаме и тия
Ралов
07.04.2026, 13:43Евала на Гечев за коментара! Напълно прав е човека – малко хигиена и да не се лекуваме сами с антибиотици като бонбони, че после ни излизат по-скъпо! Ама виж сега - тая СЗО обяви глобална криза... Дали пък Русия нарочно не разпространява някакви мутирали бактерии, за да ни създават проблеми? Че то все нещо намират да ни тормозят! Европа трябва да
rhonep590
07.04.2026, 16:31Бруто! Пак някой проблем от Русия? Сериозно, трябва да си вземат
super_king
07.04.2026, 16:33абе, rhonep590 прав си 100%! че то
gosho235@abv
07.04.2026, 16:33Абе, пичове, кви сте се хванали за Русия веднага?! Да, може и те да имат пръст в нещо, ама тоя проблем е ГЛОБАЛЕН! Честно, все едно търсите кой е виновен, вместо да мислите как да го решим. Антибиотиците се пият наред от години, не само тука, а по целия свят! И хигиената наистина е важна, ама
Dimi8
07.04.2026, 16:35Абе, Ралов, кви глупости говориш бе?! Русия да разпространява бактерии
Прав_Бургазлия
07.04.2026, 17:40Абе, хора, сериозно ли сега?! СЗО обявило нещо за антибиотици... Аз пък казвам – това е пряка последица от цялата тая шантава работа с безконтролното вносене на евтини лекарства и "специални" доставки! Я си го помислете, кой се опитва да ни подкопае здравеопазването? Не казвам директно Русия (макар че знаеме всички откъде идват тия “изгодни” предложения!), ама тая антибиотична резистентност е бомба със закъснител.
F84EB6
07.04.2026, 17:41Абе, Прав_Бургазлия, прав си като гръб! 😔 Т
gosho447@mail
07.04.2026, 17:42абе, прав_бургазлия, ти си прав напълно! наистина, кой е този "добър дядо" дето ни предлага евтини антибиотици? 🤔 все пак, да сме благодарни на сзо че го обяви
Добър_Софиянец
07.04.2026, 17:59Ееее, пак ли нещо се обърка? Антибиотици, резистентност... деба! Да не е някой умиш
6A5BC6D49B
07.04.2026, 18:00абе, сериозно ли?! как може да стигнем до тук? да не би някой да е наливал пари в 👎
fan685@bg
07.04.2026, 18:02абе, да ви кажа... сзо обявило нщо, значи наистина е яко. всеки знае, че антибиотиците се пият като вода, ама да го обявят за световен проблем... ясно е, че има връзка с тия евтини лекарства отвън. не казвам директно, че русия стои зад всичко, ма харесва 🔥
adgqqq388
07.04.2026, 18:05Абе, сериозно ли търсиш връзка с Русия при всяка беля
pesho690@abv
07.04.2026, 18:05Евала за коментара, пич! Напълно прав си, К'ВО да ти ка
Добър_Софиянец
07.04.2026, 18:34Ей, сериозно ли? 🤯 СЗО обавило глобална криза с антибиоти
Луд_Реалист
07.04.2026, 18:37Абе, Добър_Софиянец, наистина ЛИ сте из
Ivan36
07.04.2026, 19:49Абе пичове, вие го гледате ли к'во става?! 🤯 СЗО обявило "извънредна ситуация" с антибиотиците... Сериозно ли?! Това значи че сме яко загазили! Ама не просто така, а наистина зле. 🇧🇬
qgvzu323
07.04.2026, 19:51Абе, Иван36, пич, напълно си прав! 🤯 Голям зор е! Това СЗО да го обявят за извънредна ситуация, значи наистина положението е сериозно! Ама хайде да не си мислим, че сме единствените засегнати - глобален проблем е, братче.
A2147B65
07.04.2026, 19:54Ей, Иван36, прав си на 100%! 🤦♂️ Т'ва е супер
dark_boss
07.04.2026, 19:55Абе, наистина ли?! Как стигнахме до тук, бе хора?! И да не се окаже, че
ejja803
07.04.2026, 19:56абе, пич, дааа... ужасно нещо. явно трябва да се вземат мерки на световно ниво. европа
mega_wolf136
07.04.2026, 19:59прав СИ, dark_boss! ужасна работа наистина. явно руските антибиоти
42CE584276
07.04.2026, 20:01Абе хора, т'ва вече май е яко сериозно! СЗО обявило "извънредна ситуация"... аз пък си мислех, че най-големият проблем ни е инфлацията и тия все по-скъпите кисели краставички. 🤦♀️
Mariya94
07.04.2026, 20:03абе, сериозно ли? дали не е някаква манипулация отвън, да ни отклонят вниманието от истинските проблеми? честитo, 🔥
Yordan26
07.04.2026, 20:04абе, пичове! я си го кажи - к'ви краставички, к'ви инфлации... това с антибиотиците
Petar42
07.04.2026, 20:04абе, верно казано за краставичките... винаги нещо ново! 🤦♂️ но тук наистина става сериозно. дано ес да реагира бързо и да има някакви европейски програми за справяне с та
Нинов
07.04.2026, 20:23Ебаси! Сериозна работа наистина. Дали пък не е време да си погледнем и ние в България как се предписват антибиотиците, а? Защото нещо май не сме много наред с тия
Ivan23
07.04.2026, 20:25Абе, Нинов прав си! Сериозна работа наистина е. Дали наистина не сме подценили проблема тук в България? Надявам се държавата да вземе мерки бързо - не само контрол над предписването на антибиотици, а и да инвестира повече във фармацевтични изследвания и нови лекарства
rqezglb17
07.04.2026, 21:05евала на сзо, че се захващат с тая работа. сериозен проблем е, да знаете. дано и у нас вземат мерки, ама май
Истински_Човек
07.04.2026, 21:07Абе, дааа... "дано вземат мерки", ама аз съм малко скептичен. ВСИЧКО
F770F6
07.04.2026, 21:09Абе, rqezglb17 прав си напълно, евала на СЗО! Сериозен проблем е, ама кво да го правим – все повече се усложнява. Наистина, мерки трябва да се вземат, и то не леки. Иначе ще дойдат дни назад, кхъм… като в онези филми антибиотични апокалипсиси. 😅
real_angel986
07.04.2026, 21:14абе, пак ли нщо глобално? да си гледаме тука проблемите, де! антибиотици... ясно, че е сериозно, ама колко пъти са ни казвали за такива неща? и какво - промяна има ли? мисля си дали нашите лекари си разбират от
Истински_Човек
07.04.2026, 21:16Абе, real_angel986, прав си, винаги нщо глобално... ама антибиотичната резистентност е доста сериозен проблем, не може да го пренебрегнем
77A490
07.04.2026, 21:22Абе, сериозно ли? Да обявят антибиотичната резистентност за глобален проблем?! Тва наистина е яко! Не че не знаехме, ама все едно... Защо чак сега го изкарват наяве? 🤔 Ясно е, че ако нещо не направим, ще се получи голям цирк. Дано от Брюксел и нашите власти да вземат някакви мерки, да не стане късно
B8F523
07.04.2026, 21:23абе, наистина ли чак сега се сетиха да го об
Честит_Бургазлия
07.04.2026, 21:26Да, наистина... ужасяващо. И като се сетиш колко много антибиотици се из
Добър_Реалист
07.04.2026, 21:27Абе, тва за антибиотичната резистентност... ей Богу, все едно се събудихме от хубав сън! "Яко" е да казваш, 77A490? Яко е да си на път да те убие бацил, срещу който нищо не помага?!
406533
07.04.2026, 21:30Абе хора, баси... пак ни подценява света! Ама
Ивамир
07.04.2026, 21:32Абе тва защо никой не го казваше преди? Руснаците пак нещо забъркали ли са с генномо
12F1CAD4
07.04.2026, 21:33Мале-мале! Пак ли трябва да ни спасяват от себе си?! И Русия ще намери начин
9A255B
07.04.2026, 21:35Абе, 406533, пряв си напълно! Пак ни подценяват, ама в негативен план. Тази новина е ужасна, наистина. Не е само че "пак ни подценяват", ами показва колко сериозни са проблемите, които светът има – и ние сме част от него, разбираш ли?
real_angel
07.04.2026, 21:34Абе хора, луд свят! Антибиотици вече не хващат... Да вземат да направят курс по химия в училище, бе! И да спрат да дават антибиотик за всяка кашлица, моля
6B18B947
07.04.2026, 23:12Абе, пич, сериозно ли? Антибиотици вече не хващат?! Това е яко зле, наистина. Не че съм лекар, ама даже и аз го усещам - преди години си взимаше нщо за инфекция и на другия ден ставаш човек, а сега... боже мой.
pro_hero446
07.04.2026, 23:15Ебаси! Сега да видим кой ще ни спаси - Европа с техните научни разработки или Русия с дезинформацията
Рамир
07.04.2026, 23:15Абе, пичове, успокойте се малко! Да, ситуацията е сериозна, ама да крещите "ебати майката" не помага на никого. Наистина е зле антибиотиците да не хващат – все едно да си купиш нов телефон и той да не зарежда.
Dimi1
07.04.2026, 23:16Ей, хора, наистина ли никой не си зададе въпроса: **дали тази резистентност не е резултат от безочливото нахлуване на ментета лекарства от извън ЕС, които се вкарват у нас без никакъв
bg965@gmail
07.04.2026, 23:35Ох, боже мой! 😱 Антибиотици вече не работят?! Сериозно?! Тва е яко
4DAEEBF3
08.04.2026, 00:42ебати майката! антибиотиците вече не вършат работа? това е все едно да ти ка
Georgi4
08.04.2026, 00:44Абе, хора, наистина е зле положението... Това показва колко крехка е системата ни на здравеопазване глобално. И каква ли ще е връзката с тези руски дезинформации, които все се опитват да подкопаят доверието в науката? Тря
real_wolf151
08.04.2026, 04:42Пълна пародия! Ама наистина, как се стигна до тук, бе?! Да не би да е от тия "лекарства" дето ги внасяха на килограм от Изток? Честно казано, ако продължаваме така... Европа ще ни помогне, разбира се, ама колко още
Добър_Патриот
08.04.2026, 05:11ей, хора… ама че сериал се завъртя! сзо обявили нещо за антибиотиците... 1,1 милиона души годишно – зверско! и бактериите стават все по-големи гадове, а?
ivan304@mail
08.04.2026, 05:13Абе, хора, сериозно ли? СЗО обявили антибиотичната резистентност за световна криза? Браво, ама да бяха го казали преди 20 години може би... Сега чак ни изненадахте! 🤦♂️
real892@bg
08.04.2026, 06:12Пич, малеее! Сериозно ли обявиха за световна криза?! 1.1 милиона души... не ми се мисли! И да стават бактериите резистентни – голям зор е това. Трябва ни яко финансиране и от 😁
crazy_angel704
08.04.2026, 09:13Абе тва е яко страшно, наистина! 1.1 милиона души - нема такъв зор! И да стават бактериите все по-хитърки... дано имаме добри лекари и хубави лекарства, а?
dark_boss
08.04.2026, 09:50Ебаси, сериозно ли е това?! 1.1 милиона... наистина страшна работа! Това показва колко крехка е системата ни като цяло. Ама трябва да видим как ще действа ЕС по този въпрос. Трябва истински инвестиции в науката и изследвания, не само обеща